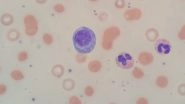
Multiple Myeloma: Know More About Kahler's Disease, a Type of Blood Cancer, Its Symptoms, Causes and Treatment

Lifestyle

Sara Khan on Special Care of Health: If You Are Fit in the Mind and Think Positive, Good Health Follows

Easter Sunday 2021: From Roast Chicken to Rosemary Roasted Potatoes, Here Are 5 Delicious Recipes to Celebrate Pascha

Katrina Kaif Shares the Key Ingredients That Defines Her Success, Says ‘Learning New Things, Finding My Flow’ (Watch Video)

Shakespeare’s Plays Could Help Medical Students Connect More Closely With Their Patients, Here’s How
Multiple Myeloma: Know More About Kahler's Disease, a Type of Blood Cancer, Its Symptoms, Causes and Treatment

Endometriosis Awareness Month 2021: From Symptoms to Care, WHO Shares Informative Tweets to Create Awareness on Endometriosis

Odisha Day 2021: From Pakhala Bhata to Dalma, Here Are 5 Delicious Odia Recipes to Celebrate Utkala Dibasa














 Quickly
Quickly











